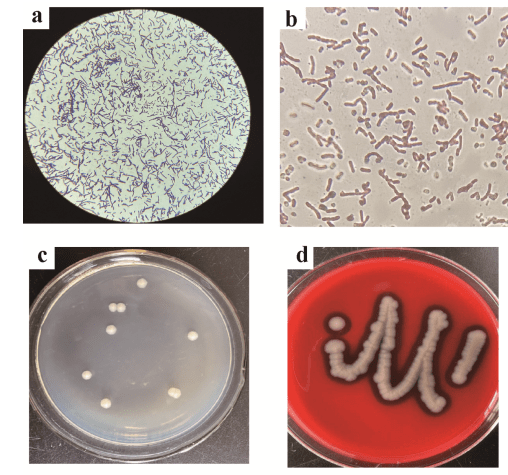
显微镜观察显示菌株gw-01是一个革兰氏阳性杆状菌,在光镜下产生出的

酵母菌阳性

02把菌液涂抹在载玻片上,接种环要在火焰中灭菌.
图片尺寸694x925
酵母菌和乳酸菌的区别?
图片尺寸640x643
9月14日csf常规培养出革兰氏阳性杆菌(见图四). ?
图片尺寸561x342
用酵母单杂交互作进行验证,将检测为阳性的酵母菌液,稀释到不同倍数
图片尺寸909x394
通过对未知微生物的特征测定,对其进行细菌,酵母菌和霉菌大类的区分
图片尺寸698x287
但生长不良,延长培养至3d,菌落呈奶油色酵母样,表面有干燥粉状物,长老
图片尺寸960x1298
关节腔积液中查出热带假丝酵母菌,导致化脓性关节炎
图片尺寸960x1280
七个月宝宝拉肚子怎么办 七个月宝宝拉肚子怎么办最快的方法小妙招
图片尺寸581x1032
酵母菌和乳酸菌的区别?
图片尺寸640x853
由酵母菌和革兰阳性细菌引起的阴道感染和继发感染硝酸咪康唑乳膏
图片尺寸800x800
试验1大肠杆菌的培养和分离.ppt 23页
图片尺寸1200x900
显微镜观察显示菌株gw-01是一个革兰氏阳性杆状菌,在光镜下产生出的
图片尺寸508x475
比如酵母菌,滴虫等成分也会导致白细胞增高,这属于假阳性
图片尺寸640x480
阴道乳酸杆菌被抑制;雌激素水平导致阴道酸碱度改变;2.
图片尺寸660x327
酵母菌的作用是什么
图片尺寸500x323
尿液分离出阿萨希毛孢子菌1例报道
图片尺寸931x1241
应该是因为衣原体才引起的吧 一个月前衣原体还是阴性的 现在变阳性了
图片尺寸1080x422
本菌细胞呈卵圆形,很象酵母菌,比葡萄球菌大5~6倍,革兰氏染色阳性,但
图片尺寸555x367
绿洲生化 霉菌酵母菌检测板 20片/盒
图片尺寸601x273
白假丝酵母定量菌株-伟业计量
图片尺寸417x556